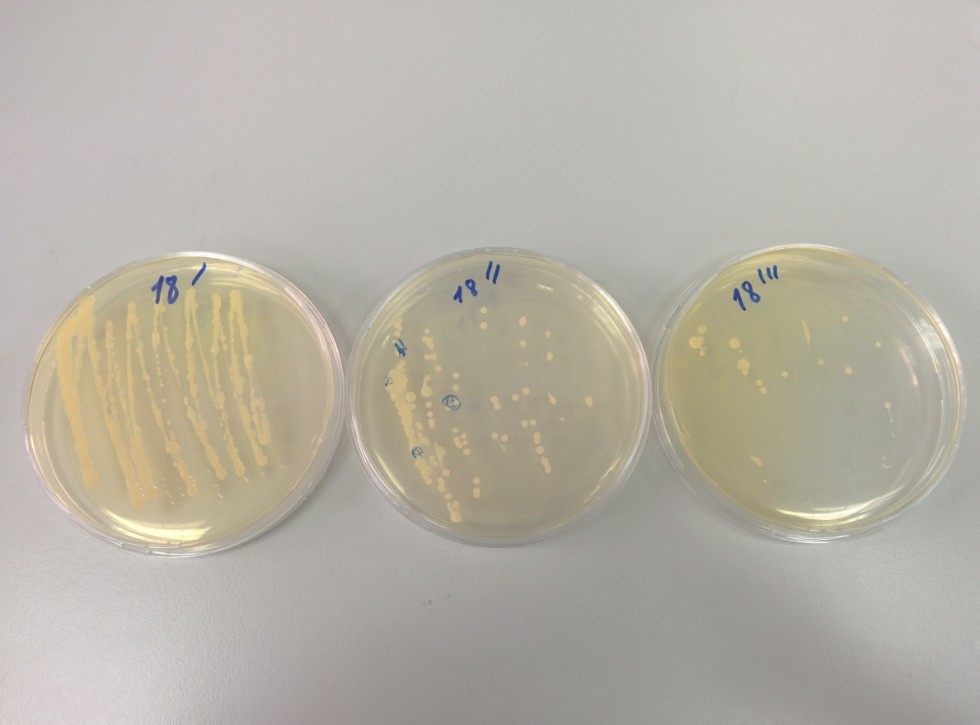
Софинансирование Софинансирование

1. Грант РНФ № 23-24-00611
«Способ получения биосурфактантов из органических отходов и исследование их потенциала в качестве интенсификаторов добычи нефтей», 2022-2024 гг. Руководитель проекта – Бикташева Л.Р. Объем финансирования – 3 000 000 руб.
Проект направлен на проведение исследований способов получения биосурфактантов и их применения в области повышения нефтеотдачи. В ходе проекта для получения биосурфактантов был произведён отбор субстратов среди отходов сельскохозяйственного и пищевого секторов производства Республики Татарстан. Из числа органических отходов были выделены микроорганизмы способные к синтезу биосурфактантов, из них была создана коллекция штаммов. Наиболее эффективными производителями биосурфактантов оказались штаммы: E. ludwigii 2pp, P. frigoritolerans 1mo, S. echinoides 2mo, Ochrobactrum sp. 5mo, S. gibsonii 6mo, B. tequilensis 1os, B. toyonensis 2os. Полученные биосурфактанты были использованы в целях биоремедиации нефтезагрязненных почв и повышения нефтеотдачи. Лабораторное моделирование процесса биоремедиации показало, что внесение биосурфактантов в загрязненную почву позволяет существенно увеличить активность аборигенной микрофлоры почв и увеличить процент деградации углеводородов на 30%. Применение биосурфактантов в целях микробного увеличения нефтеотдачи позволило повысить нефтеотдачу при третичном методе добычи на 17-19%. Также в ходе работы проводилась оценка механизма воздействия биосурфактантов на эффективность нефтедобычи. Полученные результаты были представлены на международной научно-практической конференции «Биологическая защита растений – основа стабилизации агроэкосистем», выставке TatOilExpo 2025, молодежной школе-конференции «Актуальные аспекты современной микробиологии».
2. Грант РНФ № 23-26-00275
«Сидераты как способ улавливания парниковых газов и повышения плодородия почвы», 2022-2024 гг. Руководитель проекта – Курынцева П.А. Объем финансирования – 3 000 000 руб.
3. Грант РНФ № 23-24-00611
«Вид землепользования, как фактор формирования почвенного микробного сообщества и процессов превращения почвенного органического вещества», 2024-2025 гг. Руководитель проекта – Данилова Н.В. Объем финансирования – 3 000 000 руб.
Увеличение численности населения Земли приводит к необходимости получения качественных продуктов питания на ограниченной площади земель, пригодных для ведения сельского хозяйства. Потребность в обеспечении продовольственной безопасности и независимости страны является и большим вызовом, обозначенном в Стратегии научно-технологического развития РФ. Для достижения данной цели зачастую реализуется подход ведения интенсивного сельского хозяйства, что в длительной перспективе приводит к деградации сельскохозяйственных почв, следствием чего является необходимость восстановления ее плодородия. Традиционно изменение почвенного плодородия осуществляется на основе анализа содержания гумуса или органического вещества, однако, данный параметр является крайне консервативным и для фиксации его изменения требуются многолетние наблюдения. В то же время показателями состояния почв, быстро отвечающим на почвенные изменения являются характеристик почвенных микробных сообществ, потому что именно микроорганизмы ответственны за почвенные процессы и в целом за формирование плодородия. Фактором, который наиболее часто является причиной деградации почв, является несбалансированное земледелие. В данной работе будет оценено влияние четырех видов землепользования (пашня, сенокосный луг, укос без изъятия фитомассы, залежные земли) на процессы формирования и функционирования почвенного микробного сообщества, и как следствие, на запасы почвенного углерода. Новизной данного исследования является то, что изучаемые процессы будут определены не только в пахотном горизонте, но и по профилю почвы. Выполнение данного исследования позволит оценить запас углерода послойно (0-20см, 0-30см, 0-100см) и по почвенным горизонтам. Будут охарактеризованы состав почвенного микробиома (бактериального и грибного), описано функциональное разнообразие генов в микробных сообществах угодий, на которых реализуются указанные четыре вида землепользования длительностью более 5 лет. В литературе представлен большой пул исследований, посвященных изменению агрохимических характеристик почв при разном землепользовании, однако, данные представлены в основном для верхних горизонтов, а сведения о функционировании почвенного микробиома ограничены. Полученные в нашем исследовании фундаментальные знания об изменениях в функционировании почвенного микробиома при разных типах землепользования могут лечь в основу разработки технологий ремедиации деградированных почв, рекомендаций по изменению типа землепользования и стать базисом климатических проектов.
4. Государственное задание в сфере научной деятельности № FZSM-2024-0004
"Эмиссия и сток климатически опасных газов на примере лесных и водных экосистем Среднего Поволжья и технологии секвестрации углерода живыми системами", 2024-2026 гг., руководитель - Селивановская С.Ю.
Основной целью проекта является созданная и апробированная система контроля потоков климатических газов, включающая создание программно-аппаратных комплексов прецизионных газоанализаторов, мониторинг эмиссии и стока газов в лесных и водных экосистемах наземными и дистанционными методами, в том числе на основе данных высокоскоростных измерений вихревых потоков парниковых газов, разработку новых алгоритмов анализа секвестрационного потенциала природных экосистем и биотехнологий секвестрации диоксида углерода.
В данном проекте будут реализованы несколько направлений исследований, ориентированных на реализацию основной заявленной цели, а именно, 1. мониторинг потоков климатических газов в лесной и водной экосистемах с использованием пульсационный системы, метеорологических параметров, характеристик лесных, водных и почвенных экосистем (на лесном и водном участках карбонового полигона) пульсационными (с использованием закупленных систем Eddy covariance), наземными и дистанционными методами в течение вегетационных сезонов с последующей обработкой и систематизацией данных стандартными и собственными разработанными методами; 2. разработка новых программно-аппаратных комплексов прецизионных газоанализаторов для высокоскоростных измерений малых концентраций парниковых газов по методу вихревых потоков; 3. создание алгоритма и его реализация для определения секвестрационного потенциала лесных сообществ широколиственной, хвойной и лугово-степной зон РТ; 4. Создание технологий секвестрации углекислого газа и получения полезных продуктов из биомассы водорослей, выращенных на отходящих газах в контролируемых условиях, либо удаленных из природных резервуаров, а также почвой пр различных системах обработки.
5. Хоздоговор № 0.1.1.55-15/472/24 от 18.11.2024г.
"Исследование агрохимических характеристик почв, исследование фитопатогенного фона и полезных микроорганизмов, оценка эффективности биопрепаратов для снижения развития кагатной гнили свеклы", 2024-2025 гг., руководитель - Курынцева П.А., финансирование - 4 000 000 руб.
6. Хоздоговор № 0.1.1.55-15/503/24 от 28.11.2024г.
"Разработка биопрепаратов для защиты и регуляции роста растений на основе микроорганизмов", 2024-2025 гг., руководитель - Гильмутдинова И.М., финансирование - 4 000 000 руб.